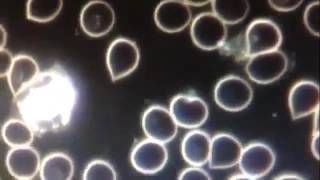
Oxidative Stress is damaged cells and this is what it looks like under microscope

Song info
"Stress" Videos
Lyrics
Too many dilemmas get in the way,
Life is compromising, there's one every day,
And there's one every day.
No more ties to bind me,
One look and know that you'll love me
I'd like to introduce you to my fine feathered friend,
And you'll loose your ????? as you slowly decend.
No more ties to bind me,
One look and know that you'll love me
She's got those magic hands they make you feel so good,
Come on baby, feelin' real good.
No more ties to bind me,
One look and know that you'll love me
Oh the world needs to be laughed at and sent far away,
Everybody's talkin's, got nothing to say,
Ain't got Nothing to say..........
But there just is tomorrow,
What I'm to plan to see today.
- 0 Bản dịch
Hiện tại chưa có lời dịch cho bài hát này. Bạn hãy là người đầu tiên chia sẻ lời dịch cho bài hát này nhé !
Đăng lời dịch

Recent comments